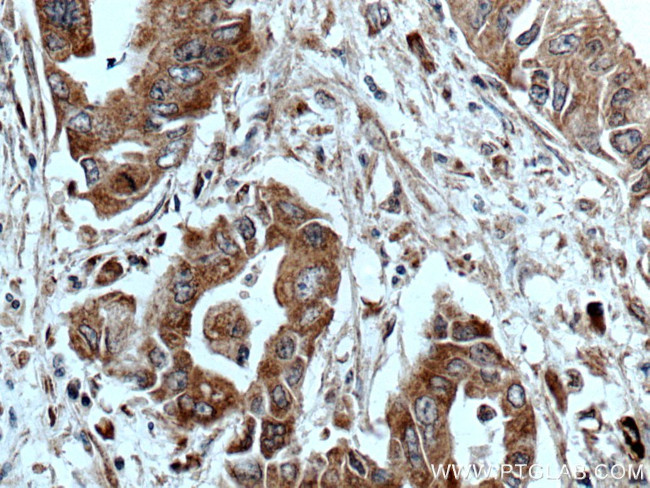
ASK1 Antibody in Immunohistochemistry (Paraffin) (IHC (P))

Search
Proteintech
ASK1 Polyclonal Antibody
{{$productOrderCtrl.translations['antibody.pdp.commerceCard.promotion.promotions']}}
{{$productOrderCtrl.translations['antibody.pdp.commerceCard.promotion.viewpromo']}}
{{$productOrderCtrl.translations['antibody.pdp.commerceCard.promotion.promocode']}}: {{promo.promoCode}} {{promo.promoTitle}} {{promo.promoDescription}}. {{$productOrderCtrl.translations['antibody.pdp.commerceCard.promotion.learnmore']}}
产品信息
28201-1-AP
种属反应
宿主/亚型
分类
类型
抗原
偶联物
形式
浓度
规格
纯化类型
保存液
内含物
保存条件
运输条件
产品详细信息
Immunogen sequence: LASESDTAD QEDLDVEDDH EEQPSNQTVR RPQAVIEDAV ATSGVSTLSS TVSHDSQSAH RSLNVQLGRM KIETNRLLEE LVRKEKELQA LLHRAIEEKD QEIKHLKLKS QPIEIPELPV FHLNSSGTNT EDSELTDWLR VNGADEDTIS RFLAEDYTLL DVLYYVTRDD LKCLRLRGGM LCTLWKAIID FRNKQT (1180-1374 aa encoded by BC054503)
靶标信息
MAP3K5 (ASK1) is a serine/threonine kinase that is abundantly expressed in human heart and pancreas and are activated in response to various extracellular stimuli, including cytokines, growth factors and environmental stresses. A novel MAP kinase kinase kinase (MAPKKK) was identified and designated ASK1 (for apoptosis signal-regulating kinase 1) and MAPKKK5. ASK1 activates two different subgroups of MAPKK, MKK4 and MKK6, which in turn activates c-Jun N-terminal kinase (JNK) and p38 MAP kinase, respectively. ASK1/MAPKKK5 is activated by TNFR and Fas through the interaction with members of the TRAF family and Fas-associated protein Daxx. Overexpression of ASK1 induced apoptotic cell death and a catalytically inactive form of ASK1 inhibited TNF-a-induced apoptosis. ASK1 is expressed in variety of human and mouse tissues.
仅用于科研。不用于诊断过程。未经明确授权不得转售。
生物信息学
蛋白别名: Apoptosis signal-regulating kinase 1; ASK 1; ASK-1; EC 2.7.11.25; kinase ASK1; M3K5; MAP/ERK kinase kinase 5; MAPK/ERK kinase kinase 5; MEK kinase 5; MEKK 5; mitogen activated protein kinase kinase kinase 5; Mitogen-activated protein kinase kinase kinase 5; RP3-325F22.4; unnamed protein product
基因别名: 7420452D20Rik; ASK; ASK1; MAP3K5; MAPKKK5; MEKK5
UniProt ID: (Human) Q99683, (Mouse) O35099
Entrez Gene ID: (Human) 4217, (Mouse) 26408